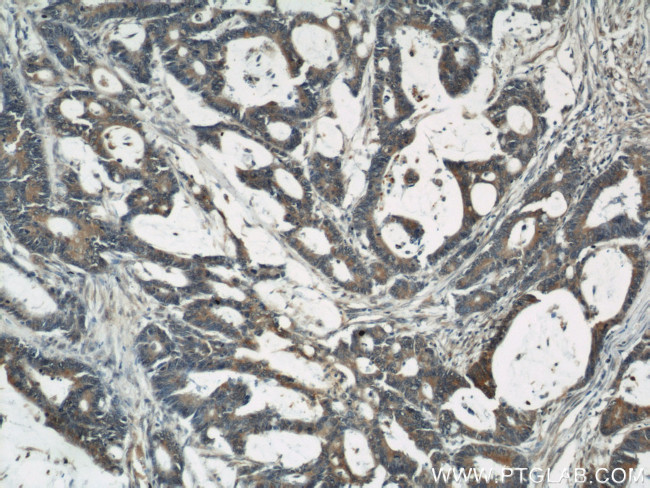
CYLD Antibody in Immunohistochemistry (Paraffin) (IHC (P))
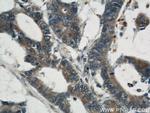
CYLD Antibody in Immunohistochemistry (Paraffin) (IHC (P))

Search
Proteintech
CYLD Polyclonal Antibody
{{$productOrderCtrl.translations['antibody.pdp.commerceCard.promotion.promotions']}}
{{$productOrderCtrl.translations['antibody.pdp.commerceCard.promotion.viewpromo']}}
{{$productOrderCtrl.translations['antibody.pdp.commerceCard.promotion.promocode']}}: {{promo.promoCode}} {{promo.promoTitle}} {{promo.promoDescription}}. {{$productOrderCtrl.translations['antibody.pdp.commerceCard.promotion.learnmore']}}
产品信息
11110-1-AP
种属反应
已发表种属
宿主/亚型
分类
类型
抗原
偶联物
形式
浓度
规格
纯化类型
保存液
内含物
保存条件
运输条件
产品详细信息
This antibody is a rabbit polyclonal antibody raised against residues near the C terminus of human CYLD.
Immunogen sequence: KIMKLRKIL EKVEAASGFT SEEKDPEEFL NILFHHILRV EPLLKIRSAG QKVQDCYFYQ IFMEKNEKVG VPTIQQLLEW SFINSNLKFA EAPSCLIIQM PRFGKDFKLF KKIFPSLELN ITDLLEDTPR QCRICGGLAM YECRECYDDP DISAGKIKQF CKTCNTQVHL HPKRLNHKYN PVSLPKDLPD WDWRHGCIPC QNMELFAVLC IETSHYVAFV KYGKDDSAWL FFDSMADRDG GQNGFNIPQV TPCPEVGEYL KMSLEDLHSL DSRRIQGCAR RLLCDAYMCM YQSPTMSLYK (657-956 aa encoded by BC012342)
靶标信息
CYLD is a 956 aa, cytoplasmic, deubiquitinating enzyme belonging to the ubiquitin carboxy-terminal hydrolases (UCH) family of proteins with three cytoskeletal-associated protein-glycine-conserved (CAP-GLY) domains, a proline rich region, a SH3 binding domain and a sequence homology to catalytic domain of UCH. CYLD is identified as a tumor suppressor protein affecting the JNK signaling pathway. CYLD is a negative regulator of TRAF2 and NF-kappa-B signaling pathway and is also known to have receptor-dependent role in regulating the I-kappa-B kinase pathway. It also has a deubiquitinating activity that is directed towards non-Lys-48-linked polyubiquitin chains and TRAP1 is a novel substrate for deubiquitination. Mutated CYLD is known to be associated with cylindromatosis, multiple familial trichoepithelioma, and Brooke-Spiegler syndrome.
仅用于科研。不用于诊断过程。未经明确授权不得转售。
生物信息学
蛋白别名: cyld; cylindromatosis (turban tumor syndrome); Deubiquitinating enzyme CYLD; FLJ20180; FLJ31664; FLJ78684; probable ubiquitin carboxyl-terminal hydrolase CYLD; retinitis pigmentosa 1 homolog; Ubiquitin carboxyl-terminal hydrolase CYLD; ubiquitin specific peptidase like 2; Ubiquitin thioesterase CYLD; ubiquitin thiolesterase CYLD; Ubiquitin-specific-processing protease CYLD; unnamed protein product
基因别名: 2010013M14Rik; 2900009M21Rik; BRSS; C130039D01Rik; CDMT; CYLD; CYLD1; CYLDI; EAC; FTDALS8; HSPC057; KIAA0849; LRRGT00003; MFT; MFT1; mKIAA0849; Rp1; Rp1h; SBS; TEM; USPL2
UniProt ID: (Human) Q9NQC7, (Rat) Q66H62, (Mouse) Q80TQ2
Entrez Gene ID: (Human) 1540, (Rat) 312937, (Mouse) 74256